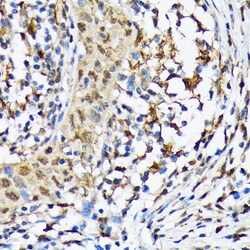
Invitrogen CaMKIV Recombinant Rabbit Monoclonal Antibody (1G4P4) 100 &mu;L;

missing translation for 'onlineSavingsMsg'
Learn More
Learn More
Invitrogen™ CaMKIV Recombinant Rabbit Monoclonal Antibody (1G4P4)


Descripción
Positive test controls include: SH-SY5Y, Mouse thymus. Immunogen sequence: EGEKIQGDGA QAAVKGAQAE LMKVQALEKV KGADINAEEA PKMVPKAVED GIKVADLELE EGLAEEKLKT VEEAAAPREG QGSSAVGFEV PQQDVILPEY.
CAMK4 (CaMKIV) is a serine/threonine protein kinase that phosphoryates CREB, oncoprotein 18, and SRF. It has limited tissue distribution, and has been implicated in transcriptional regulation in lymphocytes, neurons and male germ cells. The nuclear localization of this protein is consistent with its role in mediating calcium-dependent gene expression. CaMKIV is particularly abundant in testis, T-cells, and neurons but is also found in other tissues to varying degrees. In neurons, CaMKIV is thought to play an important role in synaptic plasticity via its gene regulatory effects. In T-cells, this protein plays an important role in calcium signaling which could affect the transcription regulatory protein, nuclear factor of activated T-cells (NFAT). CaMKIV is encoded, along with calspermin, by the CaMKIV gene. It has been found that, in testes, CaMKIV is expressed in germ cells and found to be associated with chromatin. The association of CaMKIV with chromatin suggests a potential role in chromatin remodeling during nuclear condensation in spermatids.

Especificaciones
Especificaciones
| Antígeno | CaMKIV |
| Aplicaciones | ELISA, Immunohistochemistry (Paraffin), Western Blot, Immunocytochemistry |
| Clasificación | Recombinant Monoclonal |
| Clon | 1G4P4 |
| Concentración | 0.18 mg/mL |
| Conjugado | Unconjugated |
| Formulación | PBS with 0.05% BSA, 50% glycerol and 0.02% sodium azide; pH 7.3 |
| génica | CAMK4 |
| N.º de referencia del gen | P08414, P13234, Q16566 |
| Alias de gen | A430110E23Rik; AI666733; brain Ca(2+)-calmodulin-dependent protein kinase type IV; brain Ca++-calmodulin-dependent protein kinase type IV; Ca2+/calmodulin-dependent protein kinase type IV/Gr; Calcium/calmoduli; calcium/calmodulin dependent protein kinase IV; calcium/calmodulin-dependent protein kinase IV; calcium/calmodulin-dependent protein kinase IV L homeolog; calcium/calmodulin-dependent protein kinase type IV; calcium/calmodulin-dependent protein kinase type IV catalytic chain; Calmodulin-dependent protein kinase IV; calspermin; CAM kinase- GR; CAM kinase IV; CAM kinase-GR; CAMK; CaMK IV; camk4; camk4.L; camk4-A; CAMK-GR; CAMKIV; CaMKIV/Gr; Ccdpk; D18Bwg0362e; EC 2.7.11.17; KCC4; kinase CaMK4; OTTHUMP00000222818; RATCCDPK; xCaM; XELAEV_18008011mg |
| Mostrar más |
Título del producto
Al hacer clic en Enviar, acepta que Fisher Scientific se ponga en contacto con usted en relación con los comentarios que ha proporcionado en este formulario. No compartiremos su información para ningún otro fin. Toda la información de contacto proporcionada se mantendrá de acuerdo con nuestra Política de Privacidad. Política de privacidad.
¿Detecta una oportunidad de mejora?